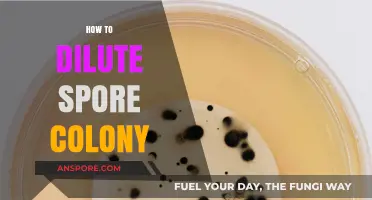
Mastering Spore Colony Dilution: A Step-by-Step Guide for Success

The Grox Empire in *Spore* is a formidable galactic force known for its aggressive expansion and dominance, making it a challenging adversary for players aiming to conquer the galaxy. Destroying the Grox requires a strategic blend of military might, diplomatic finesse, and resource management. Players must first build a strong empire by colonizing planets, advancing their technology, and forging alliances with other civilizations to counterbalance the Grox's power. Utilizing advanced weaponry, such as the Planet Buster and Rogue Asteroid, can cripple their core worlds, while leveraging espionage and trade embargoes weakens their economy. Additionally, mastering the game's mechanics, such as terraforming and space combat, is crucial for outmaneuvering their relentless fleets. With patience, planning, and creativity, dismantling the Grox Empire becomes an achievable—though epic—endeavor.
| Characteristics | Values |
|---|---|
| Empire Type | Aggressive, expansionist empire in the game Spore |
| Weaknesses | Vulnerable to alliances, economic sabotage, and direct military assault |
| Alliance Strategy | Form alliances with neighboring empires to outnumber the Grox |
| Economic Sabotage | Target their trade routes and resource-rich planets |
| Military Tactics | Use advanced weaponry, stealth, and hit-and-run strategies |
| Technological Superiority | Research and deploy higher-tier ships and weapons |
| Diplomatic Isolation | Prevent the Grox from forming alliances with other empires |
| Planet Conquest | Capture and destroy Grox-controlled planets systematically |
| Resource Deprivation | Cut off their supply lines and destroy resource-gathering outposts |
| Time Investment | Requires long-term planning and execution |
| Game Version | Strategies may vary slightly depending on Spore version (e.g., base game, expansions) |
| Player Skill | High skill in combat, diplomacy, and resource management is essential |
| Grox Behavior | Highly aggressive, with strong military and rapid expansion tendencies |
| Key Tools | Advanced spacecraft, alliances, and strategic planning |
| Difficulty Level | Considered one of the most challenging tasks in Spore |
Explore related products
What You'll Learn
- Exploit Weaknesses: Identify and target Grox vulnerabilities like resource dependencies or fleet composition flaws
- Ally with Enemies: Forge alliances with rival empires to unite against the Grox threat
- Guerilla Tactics: Use hit-and-run strategies to weaken Grox forces without direct confrontation
- Economic Sabotage: Disrupt Grox trade routes and resource supply lines to cripple their economy
- Technological Superiority: Develop advanced weapons and defenses to outmatch Grox military capabilities

Exploit Weaknesses: Identify and target Grox vulnerabilities like resource dependencies or fleet composition flaws
The Grox Empire's dominance in *Spore* hinges on its perceived invincibility, but every empire has cracks in its armor. To dismantle their control, start by dissecting their vulnerabilities. Resource dependencies are a critical weak point; the Grox rely heavily on specific materials to fuel their war machine. Identify which planets supply these resources—rare minerals, energy sources, or biological assets—and disrupt the supply chain. Sabotaging mining operations, blockading trade routes, or corrupting resource-rich worlds with rogue creatures can cripple their ability to sustain their fleets.
Fleet composition flaws offer another avenue for exploitation. While the Grox boast advanced technology, their ships often follow predictable patterns. Analyze their fleet deployments: Do they prioritize firepower over defense? Are their carriers underprotected? Use this knowledge to tailor your counterattacks. For instance, deploy swarms of small, fast ships to overwhelm their slower capital vessels, or focus on disabling their weapon systems before they can retaliate. A well-timed strike against a fleet’s weak link can turn the tide of battle.
A strategic approach involves leveraging alliances and proxies. The Grox’s aggression alienates other empires, creating natural allies in your quest. Strengthen relationships with neighboring civilizations by sharing intelligence or providing defense support. Encourage them to harass Grox borders, drawing their attention away from your operations. Alternatively, use stealth to infiltrate their systems, planting sleeper agents or viruses that degrade their infrastructure over time. Every distraction weakens their grip on the galaxy.
Finally, patience is key. The Grox Empire is vast, and direct confrontation often leads to swift retaliation. Instead, adopt a guerrilla strategy, striking at isolated outposts or resource hubs before retreating. Over time, these cumulative losses will erode their logistical capabilities and morale. Combine this with long-term efforts to fortify your own empire, ensuring you can withstand counterattacks while steadily dismantling their dominance. Exploitation of weaknesses is not about brute force—it’s about precision, persistence, and outmaneuvering the enemy at every turn.
Can Spores Legally Be Mailed to Nevada? Regulations Explained
You may want to see also

Ally with Enemies: Forge alliances with rival empires to unite against the Grox threat
The Grox Empire's dominance in *Spore* often feels insurmountable, their advanced technology and aggressive expansion leaving players scrambling for survival. Yet, history—both real and simulated—teaches us that even the mightiest empires crumble when their enemies unite. In this galactic chess game, your most potent move isn’t to outgun the Grox alone but to outmaneuver them by forging alliances with rival empires. This strategy leverages the age-old principle of "the enemy of my enemy is my friend," turning the Grox's aggression into a catalyst for unity among their targets.
To initiate such alliances, start by identifying empires under Grox pressure but not yet subjugated. These empires share your existential threat and are more likely to set aside rivalries for mutual survival. Use diplomatic tools like gift-giving, trade agreements, and defensive pacts to build trust. For instance, offering a rival empire a portion of your resources or technology can signal goodwill and demonstrate the value of cooperation. Remember, the goal isn’t to dominate these allies but to create a united front against the Grox.
However, forging these alliances isn’t without risks. Rival empires may exploit your overtures to weaken you before turning on the Grox. To mitigate this, establish clear terms in your alliances, such as joint military operations or resource-sharing agreements that benefit both parties equally. Additionally, monitor alliance members for signs of betrayal, such as sudden military buildups or unprovoked attacks. A well-timed countermeasure—like withdrawing support or forming a secondary alliance—can deter potential backstabbing.
The payoff of this strategy lies in its ability to shift the balance of power. A united coalition can pool resources, coordinate attacks, and exploit the Grox's overextended supply lines. For example, while one ally distracts the Grox with a frontal assault, another can strike at their vulnerable colonies or trade routes. Over time, this coordinated pressure erodes the Grox's ability to maintain their empire, forcing them into a defensive posture and creating opportunities for liberation.
In conclusion, allying with enemies to defeat the Grox isn’t just a tactical maneuver—it’s a strategic imperative. By transforming rivals into partners, you not only dilute the Grox's power but also strengthen your own position in the galaxy. This approach requires patience, diplomacy, and vigilance, but the rewards—a Grox-free galaxy and newfound alliances—are well worth the effort. After all, in the cosmos of *Spore*, unity isn’t just strength; it’s survival.
Understanding Oenicillium: Exploring Its Spores and Fungal Reproduction Process
You may want to see also

Guerilla Tactics: Use hit-and-run strategies to weaken Grox forces without direct confrontation
In the vast, sprawling universe of *Spore*, the Grox Empire looms as an omnipresent threat, their advanced technology and aggressive expansion making direct confrontation a perilous gamble. Guerilla tactics, however, offer a strategic counterbalance, leveraging hit-and-run strategies to chip away at their dominance without risking annihilation. By focusing on swift, targeted strikes and immediate withdrawal, players can exploit the Grox’s vulnerabilities while minimizing exposure to their overwhelming firepower.
The key to successful hit-and-run operations lies in understanding the Grox’s behavior patterns and technological weaknesses. Grox fleets are often slow to respond to small-scale attacks, and their ships, while formidable, lack agility. Players should prioritize equipping their vessels with high-speed engines and short-range weapons, such as plasma bursts or EMPs, to maximize damage during brief engagements. Striking isolated outposts or supply convoys, rather than heavily fortified planets, reduces the risk of retaliation and ensures a higher success rate.
Timing is critical in these operations. Launch attacks during periods of low Grox activity, such as when their fleets are engaged elsewhere or during system transitions. Use stealth tools, like cloaking devices or asteroid belts, to approach undetected. Once the strike is executed, retreat immediately—prolonged engagement invites counterattacks. Over time, these cumulative losses will strain the Grox’s resources, forcing them to divert attention from expansion to defense.
While guerilla tactics are effective, they require patience and discipline. Avoid the temptation to engage in prolonged battles or target high-value assets prematurely. Instead, focus on consistent, small-scale disruptions to gradually erode the Grox’s logistical and military capabilities. Think of it as a war of attrition: each successful hit weakens their grip on the galaxy, creating opportunities for larger-scale resistance efforts.
Incorporating allies into these strategies can amplify their impact. Coordinate with other empires or rogue factions to launch simultaneous strikes across multiple systems, overwhelming the Grox’s ability to respond. Share intelligence on Grox movements and vulnerabilities to refine tactics and increase efficiency. By combining hit-and-run operations with diplomatic alliances, players can transform isolated acts of defiance into a coordinated campaign to dismantle the Grox Empire from within.
Does Milky Spore Harm Butterflies? Uncovering the Truth for Gardeners
You may want to see also
Explore related products

Economic Sabotage: Disrupt Grox trade routes and resource supply lines to cripple their economy
The Grox Empire's dominance in *Spore* hinges on its ability to exploit resources and maintain efficient trade networks across the galaxy. To dismantle their power, economic sabotage emerges as a strategic linchpin. By targeting their trade routes and resource supply lines, you disrupt the very lifeblood of their economy, forcing them into a state of logistical chaos and financial strain. This approach avoids direct confrontation, leveraging asymmetry to your advantage.
To execute this strategy effectively, begin by identifying key trade hubs and resource-rich planets within Grox-controlled territories. Use the Sporepedia or in-game scanners to pinpoint high-traffic routes and vulnerable supply chains. Once identified, deploy stealthy tactics to intercept shipments. Utilize cloaking devices or ally with factions hostile to the Grox to ambush trade convoys without triggering a full-scale retaliation. Focus on destroying cargo ships rather than engaging in prolonged battles, as the goal is disruption, not annihilation.
A comparative analysis reveals that economic sabotage is more sustainable than military assaults. While direct attacks may yield temporary victories, they often strengthen the Grox's resolve and resource allocation toward defense. In contrast, economic sabotage creates long-term instability, forcing the Grox to divert resources from expansion to internal stabilization. For instance, a 30% reduction in resource flow over six in-game months can cripple their ability to fund new fleets or colonize planets, effectively stalling their galactic ambitions.
Practical tips include leveraging rogue traders or pirate factions to harass Grox supply lines. Offer them incentives, such as captured Grox technology or access to uncharted territories, to ensure their cooperation. Additionally, use terraforming tools to render resource-rich planets inhospitable, further starving the Grox economy. Remember, consistency is key—sustained disruption over time will yield the most significant results. By systematically dismantling their economic backbone, you pave the way for the Grox Empire's eventual collapse.
Can Vinegar Effectively Eliminate Airborne Mold Spores? Facts Revealed
You may want to see also

Technological Superiority: Develop advanced weapons and defenses to outmatch Grox military capabilities
The Grox Empire's military might hinges on their reliance on predictable, albeit formidable, technology. Their ships, while powerful, lack the adaptability and innovation that a technologically superior force can exploit. To dismantle their dominance, focus on asymmetric warfare: develop weapons and defenses that circumvent their strengths and target their vulnerabilities.
Step 1: Disrupt Their Energy Signature
Grox vessels rely heavily on plasma-based weaponry and shielding. Counter this by engineering weapons that emit disruptive electromagnetic pulses (EMPs) capable of temporarily neutralizing their energy systems. A well-timed EMP barrage could render a Grox fleet vulnerable, allowing for targeted strikes on their unshielded hulls. Research suggests that a concentrated EMP burst of 500 gigawatts, delivered within a 10-second window, is sufficient to overload their shielding capacitors.
Caution: EMPs are a double-edged sword. Ensure your own vessels are shielded against the effects, possibly through the use of Faraday cage-inspired hull designs.
Step 2: Exploit Their Predictable Tactics
Grox combat strategies are notoriously rigid. They favor head-on assaults, leaving their flanks exposed. Develop agile, highly maneuverable fighters equipped with precision-guided munitions. These fighters should be designed for hit-and-run tactics, striking at the Grox fleet's weaker points before retreating to safety. Incorporate advanced cloaking technology to further enhance their survivability.
"Ghost" fighters, capable of temporary invisibility, could become a thorn in the Grox's side, disrupting their formations and sowing confusion.
Analysis: While individual Grox ships are powerful, their lack of tactical flexibility is a critical weakness. By exploiting this, a technologically superior force can neutralize their numerical advantage.
Step 3: Fortify Your Defenses with Adaptive Shielding
Traditional shields are ineffective against the Grox's plasma weaponry. Invest in research on adaptive shielding technology that can dynamically adjust its frequency to counter incoming attacks. This "smart shield" system could analyze the Grox's plasma signature and generate a counter-frequency, effectively canceling out the incoming energy.
"Phase-shifting" shields, which rapidly alternate between different energy states, could further enhance their effectiveness against the Grox's predictable attack patterns.
Takeaway: Technological superiority isn't just about bigger guns; it's about smarter, more adaptable solutions. By understanding the Grox's limitations and developing countermeasures, you can turn their strength into a liability. Remember, in the face of overwhelming force, ingenuity is your greatest weapon.
Do All Milkweed Varieties Contain OE Spores? Unraveling the Myth
You may want to see also
Frequently asked questions
The Grox Empire is a powerful, hostile alien civilization in the game *Spore* known for its aggressive expansion and dominance in the galaxy.
The Grox Empire is typically found in the center of the galaxy. Use the galaxy map to identify their territory, marked by red sectors.
Focus on upgrading your weapons, armor, and tools. Ally with neighboring empires, use rogue planets to launch surprise attacks, and target their core worlds first.
While it’s possible to destroy the Grox alone with sufficient preparation, allying with other empires makes the task easier by sharing the burden of attacks.
Once the Grox are defeated, their territory becomes available for colonization, and the galaxy becomes less hostile, allowing for further exploration and expansion.